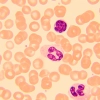
Микроскоп биологический MAGUS Bio 250B

MAGUS Bio 250B – биологический микроскоп для работы с полупрозрачными и прозрачными образцами. Оснащен бинокулярной насадкой, планахроматической оптикой и 30-ваттным галогенным осветителем проходящего света. Используется для ведения наблюдений в светлом поле, а при оснащении дополнительными аксессуарами – в темном поле, в поляризованном свете и с использованием фазово-контрастного метода. Микроскоп подходит для решения широкого круга задач в лаборатории, научно-исследовательском центре, на кафедре вуза.
Оптическая схемаВ оптической схеме используется бинокулярная насадка, в один из окулярных тубусов которой можно установить цифровую камеру. На левом тубусе корректируются диоптрии. Особенностью насадки является то, что ее окулярные тубусы вращаются на 360°, – это позволяет устанавливать высоту взора в соответствии с ростом пользователя.
5-гнездное револьверное устройство вмещает не только комплектные объективы, но и один дополнительный. Благодаря тому, что револьвер находится в положении «от наблюдателя», хорошо виден используемый объектив, а пространство над столиком свободно. Все входящие в комплект объективы являются планахроматами, что позволяет получать четкое и контрастное изображение с минимумом искажений. Диапазон увеличения оптики: от 40 до 1000 крат, верхний предел можно повысить, если оснастить микроскоп дополнительными окулярами.
Система освещения
Мощность осветителя составляет 30 Вт, поэтому при любом методе исследований и на любом объективе образец хорошо различим. Галогенная лампа излучает теплый свет, который приятен для глаз и не вызывает усталости при длительной работе с микроскопом. Есть настройка яркости. Источник питания – сеть переменного тока.
В систему освещения проходящего света входит конденсор Аббе с апертурной диафрагмой, а также полевая диафрагма. Их наличие позволяет использовать метод Кёлера при настройке освещения. В отдельный слот конденсора можно установить темнопольный или фазовый слайдер, чтобы быстро переключаться с одного метода наблюдений на другой.
Механика
Особенность этого микроскопа – отсутствие выдвижной рейки предметного столика: работа с микроскопом становится более удобной, а для его размещения требуется меньше места. Препаратоводитель плавно и точно перемещает образец и может быть снят, если в нем необходимости.
Фокусировку можно проводить грубо, регулируя жесткость хода, и тонко. Рукоятки обеих фокусировок доступны на обеих сторонах корпуса и расположены коаксиально. Грубая фокусировка имеет блокиратор хода.
Аксессуары
Для микроскопа MAGUS Bio 250B разработана линейка полностью совместимых аксессуаров: объективов и окуляров разной кратности, устройств для работы по разным методам исследований (темное поле, фазовый контраст, поляризованный свет), калибровочных слайдов и цифровых камер.
Основные особенности:
- Планахроматические объективы, рассчитанные на бесконечность
- Бинокулярный визуальный узел, диоптрийная подвижка на левом тубусе, установка цифровой камеры на место штатного окуляра
- Окулярные тубусы вращаются на 360°, что позволяет настраивать высоту взора под рост наблюдателя
- Грубый и тонкий механизмы фокусировки, у грубой фокусировки регулируется жесткость хода и есть блокиратор
- Конденсор Аббе с апертурной диафрагмой и слотом для установки слайдера (темнопольного или фазового), полевая диафрагма, возможность настройки освещения по методу Кёлера
- Галогенный осветитель проходящего света, мощность – 30 Вт, питание от сети 220 В
- Широкая линейка совместимых аксессуаров
Комплектация:
- Штатив со встроенным источником электропитания, источником проходящего света, механизмом фокусировки, предметным столиком, кронштейном конденсора и револьвером объективов
- Конденсор Аббе
- Бинокулярная визуальная насадка
- Объектив-планахромат, рассчитанный на бесконечность: 4x/0,10
- Объектив-планахромат, рассчитанный на бесконечность: 10x/0,25
- Объектив-планахромат, рассчитанный на бесконечность: 40x/0,65 (подпружиненный)
- Объектив-планахромат, рассчитанный на бесконечность: 100x/1,25 ми (подпружиненный)
- Окуляр 10x/22 мм с удаленным зрачком (2 шт.)
- Наглазник на окуляр (2 шт.)
- Светофильтр (4 шт.)
- Флакон с иммерсионным маслом
- Сетевой шнур питания для микроскопа
- Пылезащитный чехол
- Инструкция по эксплуатации и гарантийный талон
Поставляются по дополнительному заказу:
- Окуляр 10x/22 мм со шкалой
- Окуляр 12,5x/14 мм (2 шт.)
- Окуляр 15х/15 мм (2 шт.)
- Окуляр 20х/12 мм (2 шт.)
- Окуляр 25х/9 мм (2 шт.)
- Объектив-планахромат, рассчитанный на бесконечность: 20х/0,40
- Объектив-планахромат, рассчитанный на бесконечность: 60х/0,80 (подпружиненный)
- Фазово-контрастное устройство: фазовый конденсор, набор фазовых объективов, вспомогательный центрирующий телескоп
- Фазово-контрастное устройство: набор фазовых слайдеров, набор фазовых объективов, вспомогательный центрирующий телескоп
- Конденсор темного поля А 0,9
- Конденсор темного поля иммерсионный А 1,36–1,25
- Слайдер темного поля
- Устройство простой поляризации
- Цифровая камера
- Калибровочный слайд
- Адаптер C-mount
- Кольцо переходное
- Монитор
| Бренд | MAGUS (Магус) |
| Гарантия | 5 лет |
| EAN | 5905555018003 |
| Размер упаковки (ДxШxВ) | 43x27x63 см |
| Вес упаковки | 10 кг |
| Тип | биологические, световые/оптические |
| Тип насадки | бинокулярная |
| Насадка | Gemel (Зидентопф с вращением тубусов на 360°) |
| Угол наклона окулярной насадки | 30° |
| Диапазон увеличения, крат | 40 — 1000 |
| Увеличение, крат (опционально) | 40–1200/1250/1500/1600/2000/2500 |
| Диаметр окулярной трубки, мм | 30 |
| Окуляры | 10x/22, удаленный зрачок 10 мм (*опция: 10x/22 мм со шкалой, 12,5x/14 мм, 15x/15 мм, 20x/12 мм, 25x/9 мм) |
| Объективы | планахроматические, скорректированные на бесконечность: 4x/0,10; 10x/0,25; 40xs/0,65; 100xs/1,25 (масляный); парфокальная высота 45 мм (*опция: 20х/0,40; 60хs/0,80) |
| Револьверное устройство | на 5 объективов |
| Рабочее расстояние, мм | 21 (4x); 5 (10x); 0,66 (40xs); 0,36 (100xs); 8,8 (20х); 0,46 (60хs) |
| Межзрачковое расстояние, мм | 48 — 75 |
| Предметный столик, мм | 180x150 |
| Диапазон перемещения предметного столика, мм | 75/50 |
| Характеристики предметного столика | двухкоординатный механический, без выдвижной рейки |
| Возможность диоптрийной коррекции, D | ±5 (на левом тубусе) |
| Конденсор | центрируемый и регулируемый по высоте конденсор Аббе NA 1,25 с регулируемой апертурной диафрагмой и слотом для слайдера темного поля и фазового контраста; тип крепления «ласточкин хвост» |
| Диафрагма | регулируемая апертурная, регулируемая ирисовая полевая |
| Фокусировка | коаксиальная, грубая (21 мм, 39,8 мм/оборот, с механизмами блокировки и регулировки жесткости) и тонкая (0,002 мм) |
| Подсветка | галогенная |
| Регулировка яркости | ✓ |
| Источник питания | 220±22 В, 50 Гц, сеть переменного тока |
| Тип лампы подсветки | 12 В/30 Вт, цоколь G4 |
| Светофильтры | есть |
| Диапазон рабочих температур, °С | 5...+35 |
| Возможность подключения другого оборудования | фазово-контрастное устройство (конденсор и объективы), конденсор темного поля (сухой или масляный), устройство простой поляризации (поляризатор и анализатор) |
| Уровень пользователя | для опытных, для профессионалов |
| Уровень сложности сборки и настройки | сложно |
| Назначение | лабораторные/медицинские |
| Расположение подсветки | нижняя |
| Метод исследования | светлое поле |
| Чехол/кейс/сумка в комплекте | чехол пылезащитный |
| Вес, кг | 8 |
| Габариты, мм | 200x436x400 |
- Штатив со встроенным источником электропитания, источником проходящего света, механизмом фокусировки, предметным столиком, кронштейном конденсора и револьвером объективов
- Конденсор Аббе
- Бинокулярная визуальная насадка
- Объектив-планахромат, рассчитанный на бесконечность: 4x/0,10
- Объектив-планахромат, рассчитанный на бесконечность: 10x/0,25
- Объектив-планахромат, рассчитанный на бесконечность: 40x/0,65 (подпружиненный)
- Объектив-планахромат, рассчитанный на бесконечность: 100x/1,25 ми (подпружиненный)
- Окуляр 10x/22 мм с удаленным зрачком (2 шт.)
- Наглазник на окуляр (2 шт.)
- Светофильтр (4 шт.)
- Флакон с иммерсионным маслом
- Сетевой шнур питания для микроскопа
- Пылезащитный чехол
- Инструкция по эксплуатации и гарантийный талон
Поставляются по дополнительному заказу:
- Окуляр 10x/22 мм со шкалой
- Окуляр 12,5x/14 мм (2 шт.)
- Окуляр 15х/15 мм (2 шт.)
- Окуляр 20х/12 мм (2 шт.)
- Окуляр 25х/9 мм (2 шт.)
- Объектив-планахромат, рассчитанный на бесконечность: 20х/0,40
- Объектив-планахромат, рассчитанный на бесконечность: 60х/0,80 (подпружиненный)
- Фазово-контрастное устройство: фазовый конденсор, набор фазовых объективов, вспомогательный центрирующий телескоп
- Фазово-контрастное устройство: набор фазовых слайдеров, набор фазовых объективов, вспомогательный центрирующий телескоп
- Конденсор темного поля А 0,9
- Конденсор темного поля иммерсионный А 1,36–1,25
- Слайдер темного поля
- Устройство простой поляризации
- Цифровая камера
- Калибровочный слайд
- Адаптер C-mount
- Кольцо переходное
- Монитор